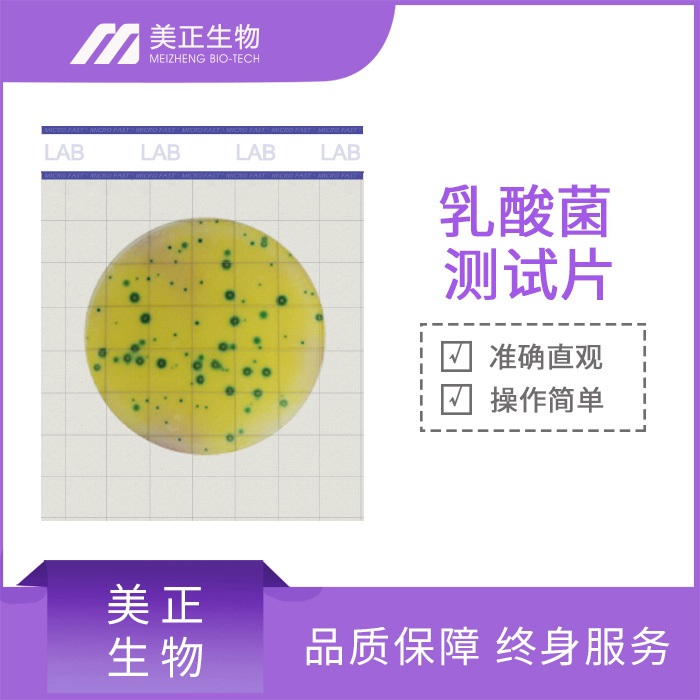
002.jpg

2024-01-25 14:43浏览量:540
乳酸菌测试片的原理是利用含有乳酸菌素等成分的特殊纸片,通过观察纸片与待检测液体接触后的变化,来判断液体中乳酸菌的数量和活性。当纸片与待检测液体接触后,乳酸菌会吸附在纸片上,随后在一定时间内产生发酵反应,使得纸片表面呈现出特定的颜色变化或出现气泡等现象。这些变化与乳酸菌的数量和活性成正比,从而可以推断出待检测液体中乳酸菌的质量。
乳酸菌测试片具有以下优势:
快速简便:使用乳酸菌测试片可以快速简便地检测出液体中乳酸菌的数量和活性,不需要复杂的实验设备和操作步骤。
准确可靠:乳酸菌测试片经过特殊设计,能够准确检测出液体中的乳酸菌,并且可靠性高,能够避免人为误差和操作不当等因素的影响。
经济实用:乳酸菌测试片成本低廉,使用方便,适合于大量检测和日常监控。同时,测试片可以重复使用,降低了检测成本。
灵活多样:根据不同的需求,可以选择不同型号的乳酸菌测试片,以满足不同液体中乳酸菌的检测要求。
安全环保:乳酸菌测试片不会产生有害物质,对环境和人体无害。同时,测试片易于处理和处置,不会对环境造成负担。
在使用乳酸菌测试片时需要注意以下几点:
正确选择适合自己需求的测试片型号,避免使用不当导致误差。
在使用前应仔细阅读使用说明,按照说明书要求进行操作。
在使用过程中要保持清洁卫生,避免污染影响测试结果。
在储存和运输过程中要注意防潮、防晒等措施,以免影响测试片的性能。